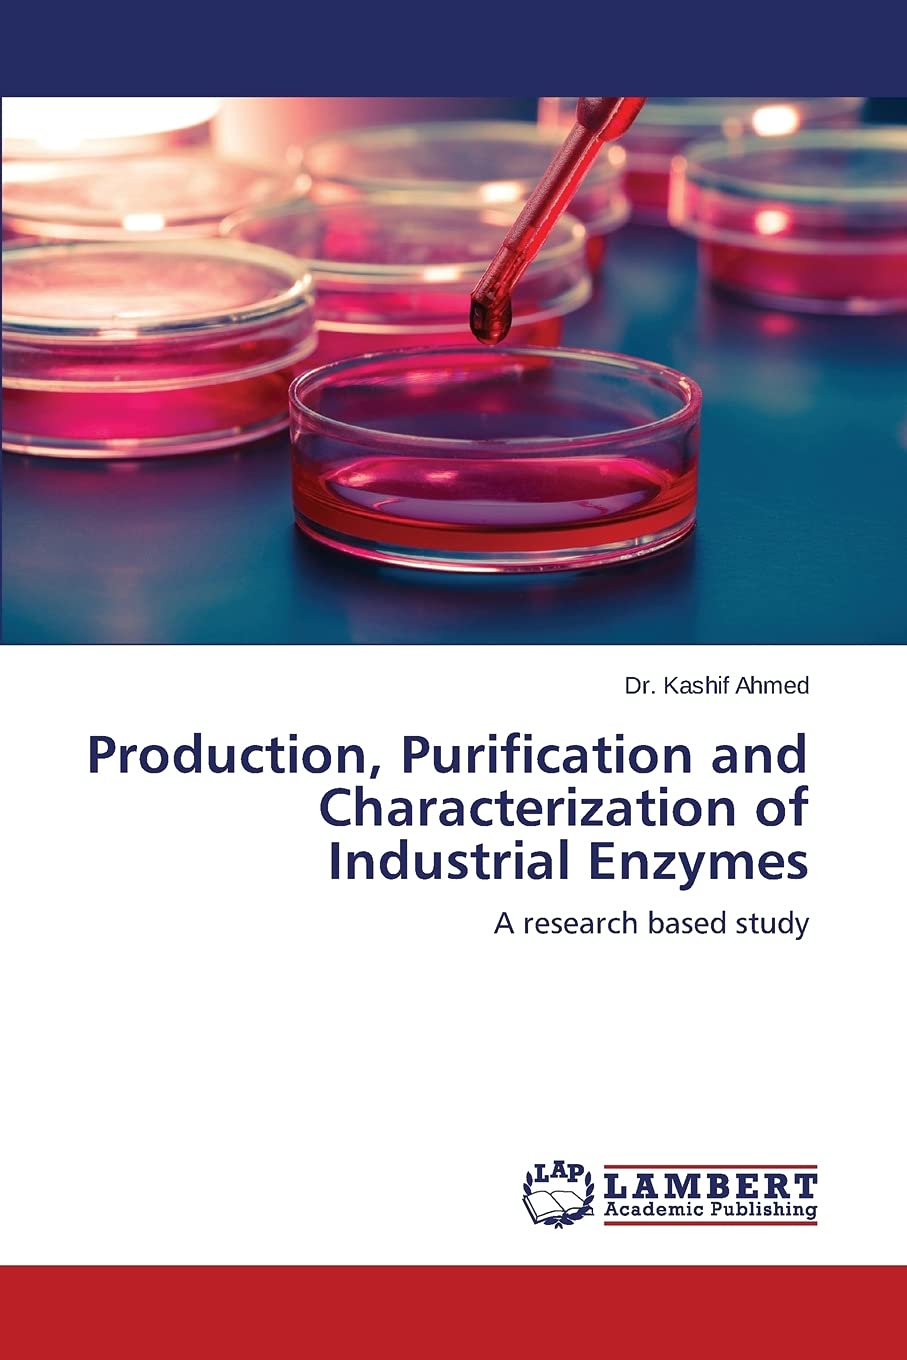

Characterizations of Exponential Distribution by Ordered Random Variables (Applied Statistical Science)
En stock
0.36 kg
No
Nuevo
Amazon
IMPORT EASILY
By purchasing this product you can deduct VAT with your RUT number
Difiere a 3 y 6 meses sin intereses con Diners, Discover y Titanium
Compra protegida
Disfruta de una experiencia de compra segura y confiable
¿Cómo comprar?
Información de Aduanas Ecuador
En Tiendamia puedes hacer tus compras a través de la categoría B (4x4) y la categoría C. No tendrás que hacer trámites de aduana. Hacemos todo por ti.
- El 4x4 (o categoría B)
- a. No paga impuestos ecuatorianos.
- b. Tienes una cantidad ilimitada de órdenes en el régimen 4x4 siempre que cada una de estas esté dentro del peso máximo permitido (hasta 4 kg) y no superen los $400, además de cumplir con el cupo anual por persona.
- c. El cupo anual máximo es de $1.600 al año para compras en el exterior a través del régimen 4x4. El cupo anual se limitan a una cédula pero no a tu usuario de Tiendamia.
- d. Se puede comprar una gran variedad de productos dentro de esta categoría siempre y cuando cumplan con el 4x4 y no sean para fines comerciales, por esa razón, se puede comprar máximo 3 productos iguales o similares de la misma categoría. Por ejemplo, puedes comprar hasta 3 perfumes, hasta 3 relojes y hasta 3 pares de zapatos, si te excedes de esta cantidad tu orden puede tener cargos extra por parte de la aduana.
- Las tablets, laptops y celulares se pueden comprar a través de la Categoría C.
- a. Esta categoría sí paga impuestos (IVA + Fodinfa)
- b. Solo se puede comprar un celular nuevo al año, no se admiten refabricados, usados u “open box.”
![]() Garantía de entrega
Garantía de entrega
Con Tiendamia todas tus compras cuentan con Garantía de Entrega o devolución total de tu dinero.
Compras 100% seguras y garantizadas, para que pidas lo que sueñas y lo recibas del mundo a tu puerta.
¿Cómo solicitar una devolución?
Para solicitar una devolución, el cliente debe realizarlo a través de su cuenta de Tiendamia. Este proceso está sujeto a la aprobación del departamento de Devoluciones (lo cual puede demorar de 48hs a 72hs hábiles). En caso de no tener la opción en la web, el cliente debe contactarse con Atención al Cliente para iniciar la solicitud.
Los productos sin devolución son:
- Los productos que tienen un tiempo de entrega mayor a 20 días hábiles.
- Productos que por su naturaleza no admiten devolución en EE.UU. o China y, por lo tanto, Tiendamia no puede ofrecer la devolución al cliente. Ejemplos: perfumes, cremas y medicamentos.
Tarjetas de Débito y Crédito

Visa

Mastercard

American Express

Dinners

Discover

Alias
Pagos a través de PayPal
Compra procesada en dólares con dinero en cuenta o tarjetas internacionales.

PayPal



.svg)